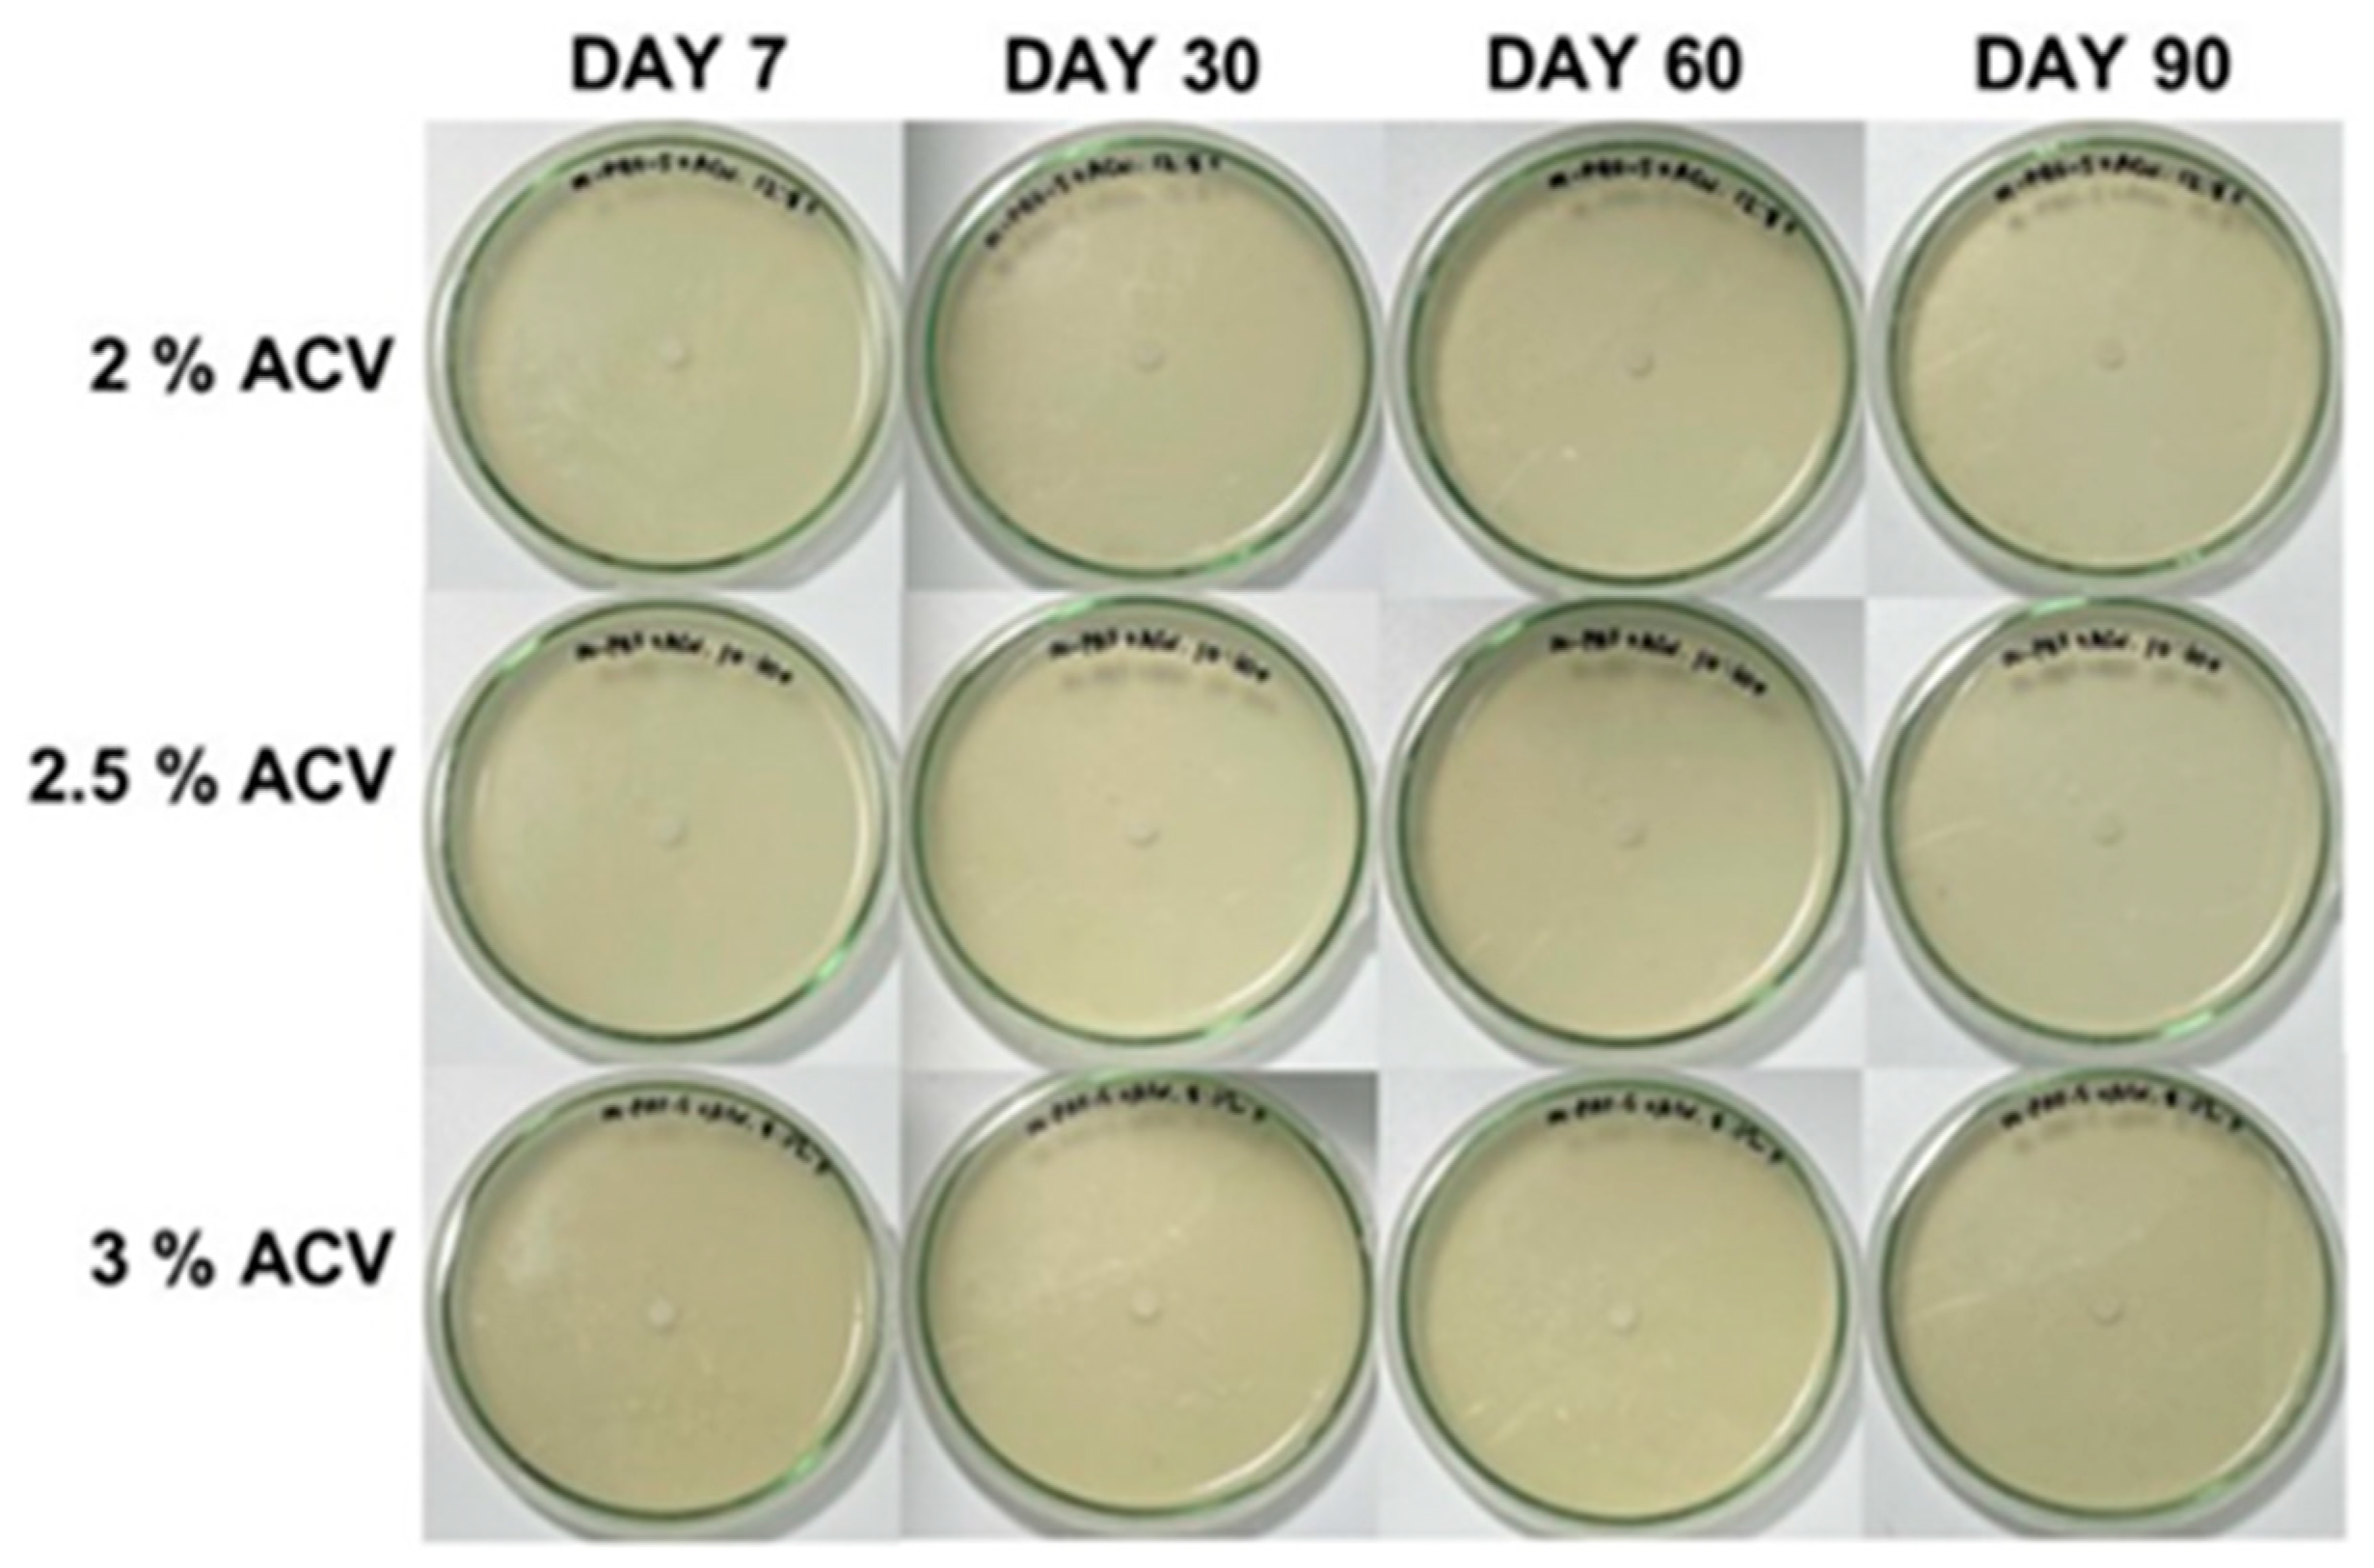
Polymers 15 01735 g006 Polymers 15 01735 g006

Antifungal Activity of Water-Based Adhesives Derived from Pineapple Stem Flour with Apple Cider Vinegar as an Additive
Abstract
1. Introduction
2. Materials and Methods
2.1. Modified PAF (m-PAF)
2.2. Water-Based Adhesives
2.3. Antifungal Activity Test
2.4. Shear Strength Test
2.5. Statistical Analysis
3. Results
3.1. ACV/PAF Water-Based Adhesives
3.1.1. Antifungal Property
3.1.2. Shear Strength of the ACV/PAF Adhesives
3.2. ACV/m-PAF Water-Based Adhesives
3.2.1. Antifungal Activity Test
3.2.2. Shear Strength of ACV/m-PAF Water-Based Adhesives
4. Conclusions
Supplementary Materials
Author Contributions
Funding
Institutional Review Board Statement
Data Availability Statement
Acknowledgments
Conflicts of Interest
References
- Adhesives and Sealants Market by Adhesive Formulating Technology (Water-Based, Solvent-Based, Hot-Melt, Reactive), Sealant Resin Type (Silicone, Polyurethane, Plastisol, Emulsion, Polysulfide, Butyl), Application, Region—Global Forecast to 2026. Available online: https://www.marketsandmarkets.com/market-reports/adhesive-sealants-market-421.html?gclid=cjwkcajwlocsbhaeeiwa3hvo_a_futuj6pu555mem1rklduxwvgxozpuiluvfifxlgf0eppsb70gjhoc8c8qavd_bwe (accessed on 30 January 2023).
- Heinrich, L.A. Future opportunities for bio-based adhesives-Advantages beyond renewability. Green Chem. 2019, 21, 1866–1888. [Google Scholar] [CrossRef]
- Boddula, R.; Mohd, I.A.; Abdullah, M.A. (Eds.) Green Adhesives: Preparation, Properties, and Applications; John Wiley & Sons: Hoboken, NJ, USA, 2020. [Google Scholar]
- Li, K.; Zuo, Y.; Zheng, L.; Wang, H.; Wu, Y. Preparation of high-strength, water-resistant starch adhesive and its bonding mechanism to cotton stalk. Ind. Crops Prod. 2023, 194, 116344. [Google Scholar] [CrossRef]
- Yin, H.; Zheng, P.; Zhang, E.; Rao, J.; Lin, Q.; Fan, M.; Zhu, Z.; Zeng, Q.; Chen, N. Improved wet shear strength in eco-friendly starch-cellulosic adhesives for woody composites. Carbohydr. Polym. 2020, 250, 116884. [Google Scholar] [CrossRef]
- Sun, J.; Li, L.; Cheng, H.; Huang, W. Preparation, characterization and properties of an organic siloxane-modified cassava Starch-Based Wood Adhesive. J. Adhes. 2018, 94, 278–293. [Google Scholar] [CrossRef]
- Din, Z.; Chen, L.; Xiong, H.; Wang, Z.; Ullah, I.; Lei, W.; Shi, D.; Alam, M.; Ullah, H.; Khan, S.A. Starch: An undisputed potential candidate and sustainable resource for the development of wood adhesive. Starch Starke 2020, 72, 1900276. [Google Scholar] [CrossRef]
- Abarca, M.L.; Bragulat, M.R.; Castella, G.; Cabanes, F.J. Ochratoxin A production by strains of Aspergillus Niger Var. niger, Appl. Environ. Microbiol. 1994, 60, 2650–2652. [Google Scholar] [CrossRef] [PubMed]
- Urbano, G.R.; Taniwaki, M.H.; de, F. Leitão, M.F.; Vicentini, M.C. Occurrence of Ochratoxin A-producing fungi in raw Brazilian coffee. J. Food Prot. 2001, 64, 1226–1230. [Google Scholar] [CrossRef]
- Battilani, P.; Pietri, A.; Bertuzzi, T.; Languasco, L.; Giorni, P.; Kozakiewicz, Z. Occurrence of Ochratoxin A-producing fungi in grapes grown in Italy. J. Food Prot. 2003, 66, 633–636. [Google Scholar] [CrossRef]
- Jin, S.; Li, K.; Gao, Q.; Zhang, W.; Chen, H.; Li, J.; Shi, S.Q. Multiple crosslinking strategy to achieve high bonding strength and antibacterial properties of double-network soy adhesive. J. Clean. Prod. 2020, 254, 120143. [Google Scholar] [CrossRef]
- He, W.; Wang, Z.; Hou, C.; Huang, X.; Yi, B.; Yang, Y.; Zheng, W.; Zhao, X.; Yao, X. Mucus-inspired supramolecular adhesives with oil-regulated molecular configurations and long-lasting antibacterial properties. ACS Appl. Mater. Interfaces 2020, 12, 16877–16886. [Google Scholar] [CrossRef]
- Aitboulahsen, M.; el Galiou, O.; Laglaoui, A.; Bakkali, M.; Hassani Zerrouk, M. Effect of plasticizer type and essential oils on mechanical, physicochemical, and antimicrobial characteristics of gelatin, starch, and pectin-based films. J. Food Process. Preserv. 2020, 44, e14480. [Google Scholar] [CrossRef]
- Resianingrum, R.; Atmaka, W.; Khasanah, L.U.; Kawiji, K.; Utami, R.; Praseptiangga, D. Characterization of cassava starch-based edible film enriched with lemongrass oil (Cymbopogon Citratus). Nus. Biosci. 2016, 8, 278–282. [Google Scholar] [CrossRef]
- Cano, A.; Cháfer, M.; Chiralt, A.; González-Martínez, C. Physical and antimicrobial properties of starch-PVA blend films as affected by the incorporation of natural antimicrobial agents. Foods 2016, 5, 3. [Google Scholar] [CrossRef]
- Kelebek, H.; Kadiroğlu, P.; Demircan, N.B.; Selli, S. Screening of bioactive components in grape and apple vinegars: Antioxidant and antimicrobial potential. J. Inst. Brew. 2017, 123, 407–416. [Google Scholar] [CrossRef]
- Ousaaid, D.; Laaroussi, H.; Bakour, M.; Ennaji, H.; Lyoussi, B.; el Arabi, I. Antifungal and antibacterial activities of apple vinegar of different cultivars. Int. J. Microbiol. 2021, 2021, 6087671. [Google Scholar] [CrossRef]
- Baysal, G.; Olcay, H.S.; Keresteci, B.; Özpinar, H. The antioxidant and antibacterial properties of chitosan encapsulated with the bee pollen and the apple cider vinegar. J. Biomater. Sci. Polym. Ed. 2022, 33, 995–1011. [Google Scholar] [CrossRef]
- Baldas, B.; Altuner, E. The antimicrobial activity of apple cider vinegar and grape vinegar, which are used as a traditional surface disinfectant for fruits and vegetables. Commun. Fac. Sci. Univ. Ank. Ser. C Biol. Geol. Eng. Geophys. Eng. 2018, 27, 1–10. [Google Scholar]
- Yagnik, D.; Serafin, V.; Shah, A.J. Antimicrobial activity of apple cider vinegar against Escherichia coli, Staphylococcus aureus and Candida albicans; Downregulating Cytokine and microbial protein expression. Sci. Rep. 2018, 8, 1732. [Google Scholar] [CrossRef]
- Rutala, W.A.; Barbee, S.L.; Aguiar, N.C.; Sobsey, M.D.; Weber, D.J. Antimicrobial activity of home disinfectants and natural products against potential human pathogens. Infect. Control Hosp. Epidemiol. 2000, 21, 33–38. [Google Scholar] [CrossRef]
- Popular Ways People Use Apple Cider Vinegar for Household Cleaning. Available online: https://www.northcoast.organic/popular-ways-people-use-apple-cider-vinegar-for-household-cleaning/ (accessed on 3 March 2023).
- Ojogbo, E.; Blanchard, R.; Mekonnen, T. Hydrophobic and melt processable starch-laurate esters: Synthesis, structure–property correlations. J. Polym. Sci. Part A-1 Polym. Chem. 2018, 56, 2611–2622. [Google Scholar] [CrossRef]
- Su, H.F.; Chen, H.; Lin, J.F. A sequential integration approach using Aspergillus niger to Intensify coal fly ash as a rare metal pool. Fuel 2020, 270, 117460. [Google Scholar] [CrossRef]
- Larregle, A.; Chalapud, M.; Fangio, F.; Ciannamea, E.M.; Stefani, P.M.; Martucci, J.F.; Ruseckaite, R.A. Antifungal soybean protein concentrate adhesive as binder of rice husk particleboards. Polymers 2021, 13, 3540. [Google Scholar] [CrossRef] [PubMed]
- Pourakbar, L.; Moghaddama, S.S.; el Enshasy, H.A.; Sayyed, R.Z. Antifungal activity of the extract of a macroalgae, Gracilariopsis persica, against four plant pathogenic fungi in vitro. Plants 2021, 10, 1781. [Google Scholar] [CrossRef] [PubMed]
- Wang, J.-J.; Zhang, H.-P.; Tang, S.-C.; Liang, Y. Effects of Particle size distribution on shear strength of accumulation soil. J. Geotech. Geoenviron. 2013, 139, 1994–1997. [Google Scholar] [CrossRef]
- SPSS Inc. Released 2009. PASW Statistics for Windows, Version 18.0; SPSS Inc.: Chicago, IL, USA, 2009. [Google Scholar]
- Politz, M.L.; Timpa, J.D.; White, A.R.; Wasserman, B.P. Non-aqueous gel permeation chromatography of wheat starch in dimethylacetamide (DMAC) and LiCl: Extrusion-Induced Fragmentation. Carbohydr. Polym. 1994. 24, 91–99. [CrossRef]
- Lehmann, A.; Volkert, B.; Hassan-Nejad, M.; Greco, T.; Fink, H.P. Synthesis of thermoplastic starch mixed esters catalyzed by the in-Situ generation of imidazolium salts. Green Chem. 2010, 12, 2164–2171. [Google Scholar] [CrossRef]
- Winkler, H.; Vorwerg, W.; Wetzel, H. Synthesis and properties of fatty acid starch esters. Carbohydr. Polym. 2013, 98, 208–216. [Google Scholar] [CrossRef]
- Saqib, A. Antimicrobial activity of apple cider vinegar. Mapana J. Sci. 2017, 16, 11–15. [Google Scholar] [CrossRef]
- Kara, M.; Assouguem, A.; Al Kamaly, O.M.; Benmessaoud, S.; Imtara, H.; Mechchate, H.; Hano, C.; Zerhouni, A.R.; Bahhou, J. The impact of apple variety and the production methods on the antibacterial activity of vinegar samples. Molecules 2021, 26, 5437. [Google Scholar] [CrossRef]
- Madshus, I.H. Regulation of intracellular pH in eukaryotic cells. Biochem. J. 1988, 250, 1–8. [Google Scholar] [CrossRef]
- Aurelio, L.M.; Stella, M.A.; Enrique, P. Aspergillus flavus growth in the presence of chemical preservatives and naturally occurring antimicrobial compounds. Int. J. Food Microbiol. 2005, 99, 119–128. [Google Scholar] [CrossRef]
- Plumridge, A.; Hesse, S.J.A.; Watson, A.J.; Lowe, K.C.; Stratford, M.; Archer, D.B. The weak acid preservative sorbic acid inhibits conidial germination and mycelial growth of Aspergillus niger through intracellular acidification. Appl. Environ. Microbiol. 2004, 70, 3506–3511. [Google Scholar] [CrossRef] [PubMed]
- Mota, A.C.L.G.; de Castro, R.D.; de Araújo Oliveira, J.; de Oliveira Lima, E. Antifungal activity of apple cider vinegar on Candida species involved in Denture Stomatitis. J. Prosthodont. 2015, 24, 296–302. [Google Scholar] [CrossRef]
- Bouarab-Chibane, L.; Forquet, V.; Lantéri, P.; Clément, Y.; Léonard-Akkari, L.; Oulahal, N.; Degraeve, P.; Bordes, C. Antibacterial Properties of Polyphenols: Characterization and QSAR (Quantitative Structure-Activity Relationship) models. Front. Microbiol. 2019, 10, 829. [Google Scholar] [CrossRef] [PubMed]
- Malicki, A.; Zawadzki, W.; Bruzewicz, S.; Graczyk, S.; Czerski, A. Effect of formic and propionic acid mixture on Escherichia coli in Fish Meal Stored at 12 °C. Pak. J. Nutr. 2004, 3, 353–356. [Google Scholar] [CrossRef]
- Uhre Guldfeldt, L.; Arneborg, N. Measurement of the Effects of acetic acid and extracellular pH on intracellular pH of nonfermenting, individual Saccharomyces cerevisiae cells by fluorescence microscopy. Appl. Environ. Microbiol. 1998, 64, 530–534. [Google Scholar] [CrossRef]
- Prudêncio, C.; Sansonetty, F.; Côrte-Real, M. Flow Cytometric Assessment of cell structural and functional changes induced by acetic acid in the yeasts Zygosaccharomyces bailii and Saccharomyces cerevisiae. Cytometry 1998, 31, 307–313. [Google Scholar] [CrossRef]
- Arneborg, N.; Jespersen, L.; Jakobsen, M. Individual Cells of Saccharomyces Cerevisiae and Zygosaccharomyces bailii Exhibit different short-term intracellular pH responses to acetic acid. Arch. Microbiol. 2000, 174, 125–128. [Google Scholar] [CrossRef]
- Samber, N.; Khan, A.; Varma, A.; Manzoor, N. Synergistic Anti-candidal activity and mode of action of Mentha piperita essential oil and its major components. Pharm. Biol. 2015, 53, 1496–1504. [Google Scholar] [CrossRef]
- Juniper, S.; Abbott, L.K. Soil salinity delays germination and limits growth of hyphae from propagules of Arbuscular Mycorrhizal fungi. Mycorrhiza 2006, 16, 371–379. [Google Scholar] [CrossRef]
- Jahromi, F.; Aroca, R.; Porcel, R.; Ruiz-Lozano, J.M. Influence of salinity on the in vitro development of Glomus intraradices and on the in vivo physiological and molecular responses of Mycorrhizal lettuce plants. Microb. Ecol. 2008, 55, 45–53. [Google Scholar] [CrossRef] [PubMed]
- Schrekker, H.S.; Donato, R.K.; Fuentefria, A.M.; Bergamo, V.; Oliveira, L.F.; Machado, M.M. Imidazolium salts as antifungal agents: Activity against emerging yeast pathogens, without human Leukocyte toxicity. Medchemcomm 2013, 4, 1457–1460. [Google Scholar] [CrossRef]
- Nadig, P.; Shetty, S. Comparative evaluation of antimicrobial effect of-ginger, apple cider vinegar, and fruit vinegar-an in vitro UV spectrophotometric study. Int. J. Sci. Res. 2019, 8, 2289–2293. [Google Scholar] [CrossRef]
- Gopal, J.; Anthonydhason, V.; Muthu, M.; Gansukh, E.; Jung, S.; Chul, S.; Iyyakkannu, S. Authenticating apple cider vinegar’s home remedy claims: Antibacterial, antifungal, antiviral properties and cytotoxicity aspect. Nat. Prod. Res. 2019, 33, 906–910. [Google Scholar] [CrossRef] [PubMed]

| Sample | Mw (Da) | Mn (Da) | Polydispersity Index | Degree of Substitution |
|---|---|---|---|---|
| PAF | 2.02 × 106 | 1.97 × 106 | 1.03 | 0.00 |
| m-PAF | 3.44 × 106 | 3.32 × 106 | 1.03 | 0.13 |
| Sample/Day | Mycelial Growth (mm) | |||||||
|---|---|---|---|---|---|---|---|---|
| 0 | 1 | 2 | 3 | 4 | 5 | 6 | 7 | |
| Control | 0.0 a | 0.0 a | 21.0 ± 1.5 a | 26.8 ± 1.5 a | 32.5 ± 1.7 a | 37.7 ± 1.4 a | 44.6 ± 1.1 a | 48.9 ± 0.6 a |
| PAF | 0.0 a | 0.0 a | 17.3 ± 0.8 b | 25.5 ± 0.8 a | 30.6 ± 1.0 a | 35.5 ± 1.0 a | 42.5 ± 1.3 a | 44.4 ± 0.8 a |
| 0.3% ACV/PAF | 0.0 a | 0.0 a | 19.2 ± 0.2 ab | 23.5 ± 0.6 ab | 28.1 ± 0.6 a | 33.9 ± 1.8 a | 38.9 ± 2.0 a | 44.7 ± 1.1 a |
| 0.625% ACV/PAF | 0.0 a | 0.0 a | 14.1 ± 2.9 c | 20.9 ± 1.5 b | 26.8 ± 1.9 a | 32.8 ± 0.7 a | 38.6 ± 1.2 a | 44.2 ± 1.7 a |
| 1.25% ACV/PAF | 0.0 a | 0.0 a | 0.0 d | 3.2 ± 5.5 c | 8.0 ± 7.7 b | 11.9 ± 11.4 b | 16.5 ± 15.1 b | 20.7 ± 18.8 b |
| 2.0% ACV/PAF | 0.0 a | 0.0 a | 0.0 d | 0.0 c | 0.0 c | 0.0 c | 0.0 c | 0.0 c |
| 2.5% ACV/PAF | 0.0 a | 0.0 a | 0.0 d | 0.0 c | 0.0 c | 0.0 c | 0.0 c | 0.0 c |
| 3.0% ACV/PAF | 0.0 a | 0.0 a | 0.0 d | 0.0 c | 0.0 c | 0.0 c | 0.0 c | 0.0 c |
| Sample/Day | Mycelial Growth (mm) | |||||||
|---|---|---|---|---|---|---|---|---|
| 0 | 1 | 2 | 3 | 4 | 5 | 6 | 7 | |
| Control | 0.0 a | 0.0 a | 21.0 ± 1.5 a | 26.8 ± 1.5 a | 32.5 ± 1.7 a | 37.7 ± 1.4 a | 44.6 ± 1.1 a | 48.9 ± 0.6 a |
| m-PAF | 0.0 a | 0.0 a | 19.5 ± 0.8 b | 27.3 ± 1.5 a | 34.2 ± 0.8 a | 39.8 ± 0.9 a | 44.6 ± 1.6 a | 49.1 ± 2.7 a |
| 0.3% ACV | 0.0 a | 0.0 a | 19.3 ± 1.1 b | 24.3 ± 1.8 b | 31.9 ± 4.5 a | 38.0 ± 5.3 a | 42.5 ± 5.3 a | 46.6 ± 3.1 a |
| 0.625% ACV | 0.0 a | 0.0 a | 17.6 ± 1.0 c | 23.3 ± 0.4 b | 27.5 ± 0.8 a | 32.1 ± 1.2 a | 37.2 ± 0.8 a | 42.4 ± 0.5 a |
| 1.25% ACV | 0.0 a | 0.0 a | 0.0 d | 0.0 c | 6.31 ± 1.0 b | 8.2 ± 14.2 b | 15.0 ± 14.2 b | 21.5 ± 13.8 b |
| 2.0% ACV | 0.0 a | 0.0 a | 0.0 d | 0.0 c | 0.0 b | 0.0 b | 0.0 c | 0.0 c |
| 2.5% ACV | 0.0 a | 0.0 a | 0.0 d | 0.0 c | 0.0 b | 0.0 b | 0.0 c | 0.0 c |
| 3.0% ACV | 0.0 a | 0.0 a | 0.0 d | 0.0 c | 0.0 b | 0.0 b | 0.0 c | 0.0 c |
| Organism | Antifungal Agent | Test Method | Diameter of Zone Inhibition/Inhibition Efficiency | Remark | Ref. |
|---|---|---|---|---|---|
| Candida albicans | ACV | Agar well diffusion method | 12 mm | Cell integrity damage, Disturbed structure of metabolic protein, and nuclei. | [20] |
| Candida albicans (ATCC 18804) | ACV and fruit vinegar | Agar well diffusion method | 11 mm | Impaired cell integrity, Disrupted organelles and protein expression. | [47] |
| Fruit vinegar | 20.5 mm | ||||
| Candida tropicalis | ACV | Agar well diffusion method | 11–12 mm | Acidic pH induced the fungi membrane cell destruction. Phenolics induced growth inhibition of microbes. Polyphenols disturb the membrane cells integrity. | [17] |
| Candida albicans Aspergillus niger | ACV | Agar well diffusion method | C. albicans; 20.8 ± 0.4 mm | Lowering of cellular pH. | [32] |
| A. niger; 26.6 ± 0.5 mm | |||||
| Candida albicans | ACV (1, 10, 25, 50, 100%) | Agar well diffusion method | 100% ACV; 6 mm | Phenolic compounds are antifungal agents. | [48] |
| Aspergillus niger | 100% ACV; 25 mm | ||||
| 50% ACV; 10 mm | |||||
| 25% ACV; 3 mm | |||||
| Candida albicans DSMZ, 1386 | ACV | Minimum inhibitory concentration (MIC) | Ineffective | - | [19] |
| Grape vinegar | 50 ug/mL | ||||
| Escherichia. coli Pseudomonas aeruginosa Klebsiella pneumonia Staphylococcus aureus | Apple vinegar | Agar well diffusion method | E. coli; 17.3 ± 0.6 mm | By inhibiting bacterially produced -lactamases and topoisomerase enzymes, flavonoids can also inactivate the efflux pump and cause the cytoplasmic membrane to become unstable. Catechins cause lipopolysaccharide to degrade, and the degradation products function as a barrier in the bacterial membranes. | [33] |
| P. aeruginosa; 32.7 ± 2.5 mm | |||||
| K. pneumonia; 17.3 ± 0.6 mm | |||||
| S. aureus; 20.7 ± 1.2 mm | |||||
| Minimum inhibitory concentration (MIC) (µL/mL) | E. coli; 7.81 | ||||
| P. aeruginosa; 3.91 | |||||
| K. pneumonia; 3.91 | |||||
| S. aureus; 7.81 | |||||
| Minimum bacterial concentration (MBC) (µL/mL) | E. coli; 15.62 | ||||
| P. aeruginosa; 7.81 | |||||
| K. pneumonia; 15.62 | |||||
| S. aureus; 15.62 | |||||
| Listeria monocytogenes Staphylococcus aureus Escherichia coli Salmonella | Chitosan encapsulated with ACV | Agar well diffusion method | L. monocytogenes; 908.0 ± 0.0 mm2 | Phenolic compounds are antifungal agents. | [18] |
| S. aureus; 314.0 ± 0.0 mm2 | |||||
| E. coli; 201.0 ± 0.0 mm2 | |||||
| Salmonella; 314.0 ± 0.0 mm2 | |||||
| Aspergillus niger | ACV in water glue derived from the native PAF starch | Mycelial growth inhibition | 2–3% v/v, 100% inhibition | Organic acids, phenolics in ACV are antifungal agents. | This study |
| ACV in water glue derived from the esterified PAF starch | Antifungal agents are organic acids, phenolics in ACV, and salts generated from acid-base neutralization. | This study |
Disclaimer/Publisher’s Note: The statements, opinions and data contained in all publications are solely those of the individual author(s) and contributor(s) and not of MDPI and/or the editor(s). MDPI and/or the editor(s) disclaim responsibility for any injury to people or property resulting from any ideas, methods, instructions or products referred to in the content. |
© 2023 by the authors. Licensee MDPI, Basel, Switzerland. This article is an open access article distributed under the terms and conditions of the Creative Commons Attribution (CC BY) license (https://creativecommons.org/licenses/by/4.0/).
Share and Cite
Ninsuwan, K.; Nimnuan, J.; Watcharakitti, J.; Siriwong, C.; Amornsakchai, T.; Smith, S.M. Antifungal Activity of Water-Based Adhesives Derived from Pineapple Stem Flour with Apple Cider Vinegar as an Additive. Polymers 2023, 15, 1735. https://doi.org/10.3390/polym15071735
Ninsuwan K, Nimnuan J, Watcharakitti J, Siriwong C, Amornsakchai T, Smith SM. Antifungal Activity of Water-Based Adhesives Derived from Pineapple Stem Flour with Apple Cider Vinegar as an Additive. Polymers. 2023; 15(7):1735. https://doi.org/10.3390/polym15071735
Chicago/Turabian StyleNinsuwan, Kamonlak, Jaturavit Nimnuan, Jidapa Watcharakitti, Chomsri Siriwong, Taweechai Amornsakchai, and Siwaporn Meejoo Smith. 2023. "Antifungal Activity of Water-Based Adhesives Derived from Pineapple Stem Flour with Apple Cider Vinegar as an Additive" Polymers 15, no. 7: 1735. https://doi.org/10.3390/polym15071735
APA StyleNinsuwan, K., Nimnuan, J., Watcharakitti, J., Siriwong, C., Amornsakchai, T., & Smith, S. M. (2023). Antifungal Activity of Water-Based Adhesives Derived from Pineapple Stem Flour with Apple Cider Vinegar as an Additive. Polymers, 15(7), 1735. https://doi.org/10.3390/polym15071735

